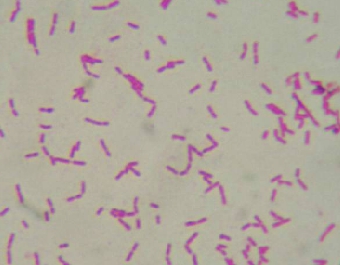

Contaminazioni nelle produzioni alimentari

In questa pagina puoi scaricare le dispense sulle varie tipologie di contaminazioni alimentari e dell'ambiente.
il biofilm nellindustria alimentare
listeria monocytogens
legionella
salmonella
muffe e lieviti
pseudomonas - acque minerali
la disinfezione dellaria
Powered by Phoca Download